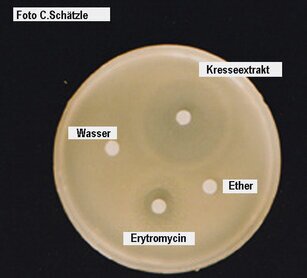

44Biotechnaturstoffe
SEKUNDARSTUFEN
44biotecnaturstoffe
Biotechnik 3:
Gewinnung von Naturstoffen
Experimente und Informationen:
Naturstoffe im Dienst des Menschen Auf der Suche nach immer neuen für Industrie und Mensch nützlichen Substanzen hat man gefunden, dass viele Pflanzen und Tiere Substanzen enthalten, die als Medikamente, als Baustoffe oder als Farbstoffe zu verwenden sind. Suche und Forschung zu diesen Naturstoffen sind in vollem Gange. Hier sollen einige Beispiele experimentell konkretisiert werden. | ||
Biotechnik 1: Gewinnung von Eiweiß
Klautke, P.
vereinfacht nach Klautke (1984): Brot aus Algen, UB S.31ff
Gewinnung von Eiweiß als Nahrungsbestandteil Info: Die Gewinnung von Eiweiß für die menschliche Ernährung aus Pflanzen oder Tieren wird zunehmend schwieriger. Daher versucht man, aus schnellwachsenden Lebewesen Eiweiß als Tierfutter oder als Nahrung für den Menschen in großtechnischem Rahmen zu gewinnen. Ansätze dazu sind Fischfarmen, aber auch die Landwirtschaft mit neuen Nahrungsmittelpflanzen. Übersicht: Verdopplung der Biomasse bei Bakterien: 20-60 Minuten; bei Hefe: 2- 4 Stunden; bei Algen: 6-48 Stunden, bei Gras: 1- 2 Wochen; Huhn: 3- 4 Wochen; Schwein: 4- 6 Wochen; Rind: 4- 8 Wochen. Aus der Zusammenstellung ergibt sich, dass die Gewinnung von Eiweiß aus Hefen oder einzelligen Algen große Vorteile bringen würde. Die Forschung nach alternativer Gewinnung von Eiweiß hat in den letzten Jahren erheblich zugenommen, um den Eiweißbedarf der Menschheit zu befriedigen. Wachstum von Clorella: Das Wachstumsexperiment ist stellvertretend für andere Methoden der Eiweissgewinnung gedacht. Der Vorteil ist: Chlorella hat grün gefärbte Chloroplasten und das Wachstum des Einzellers ist leicht zu verfolgen. Chlorella hat sich aber nicht als Nahrungsbestandteil durchgesetzt, da die Wand der Zellen unverdaulich ist. Andere Ansätze sind: Aquafarmen mit Fischen in Meerwasser, Forellenzucht im Schwarzwald, Fischvermehrung in Fabriken in großen Tanks mit Nährlösungen, Pflanzenzucht in Gewächshäusern, Massentierhaltung von Schweinen. Jede Methode hat ihre Nachteile. | ||
Versuch 1
Vermehrung von Einzellern
Aufgabe: Nachweis des Algenwachstums in Abhängigkeit von der Konzentration der Nährlösung (flüssiger Blumendünger nach Vorschrift angesetzt und entsprechend konzentriert und verdünnt).
Geräte: Belichtungsmesser zur Trübungsmessung, Apparatur nach Abbildung
Lebewesen: Clorella- Algen Probe bei: info@algomed.de mit definiertem Ausgangsmaterial.

Eigene Messungen:
1) Als Trübungsmessung mit einem Belichtungsmesser
2) Mikrokopische Untersuchung:
Dazu bringt man die Suspensionen auf einen Objektträger, tötet kurz über einer Kerzenflamme ab und zählt die Algen in einem Millimeter eines untergelegten Millimeterpapiers aus.
https://www.proplanta.de/agrar-nachrichten/pflanze/koernerleguminosen-sind-die-zukunft_article1549701174.html
Aufgaben: Interpretieren Sie Ihre Daten! Informieren Sie sich über die neuesten Entwicklungen auf diesem Gebiet der Algenzüchtung und der Produktentwicklung.
Lit:
Rehm, H. J. (2013): Industrielle Mikrobiologie, Taschenbuch Springer; Proteinlabor: http://www.lab-academy.de/b502.html;
Algenfarm: http://www.algomed.de/index.php?op=algenfarm_anlage
Klautke, S. (1984): Brot aus Algen IN: Schneider, V. u. W. Probst (1984): Biologische Prozesse in der Biologie, UB 90, Febr 1984, 31ff.
https://de.wikipedia.org/wiki/Protein
https://cordis.europa.eu/article/id/125046-proteinrich-alternatives-to-meat-for-a-sustainable-future/de
Biotechnik 2: Gewinnung von Duftstoffen
Schneider, V.
Duftstoffe - Grundlagen für die Parfümindustrie
Duftstoffe für Industrie und Kosmetik Obwohl wir Menschen rund 200fach schlechter riechen können als Hunde, spielt Riechen für uns doch eine große Rolle. Das zeigt sich schon an der Bemerkung: „Ich kann den nicht riechen!“ Auch das Gerücht, das sich rasend schnell in der Stadt verbreitet, hat Riechen im Wortstamm. In der Religion spielte das Rauchopfer eine große Rolle, Parfüm (= par fumum = durch Rauch) bedeutete ursprünglich, sich die Gottheit „durch ein Rauchopfer“ gewogen zu machen. In der Zeit der Römer wurde „gut riechen“ privatisiert und zu einem Statussymbol: die reichen Römer parfümierten so gut wie alles. Erst durch das Christentum wurde Parfüm in Misskredit gebracht, wohl weil Duftstoffe im alten Rom viel Geld gekostet haben. Allein der Weihrauch durfte in Kirchen noch verwendet werden. Im heutigen Leben sind Parfüme für alle käuflich geworden. Parfümeure (Berufsbezeichnung: „Die Nasen“) kreieren immer neue Duftkombinationen. Der Markt nimmt immer noch zu, trotz der Preise, die verlangt und bezahlt werden. Räucherstäbchen sind Mode. - -- Kurz, wir entkommen nicht den Gerüchen! Sinnesorgane für Riechen:  Weg der Duftstoffe (Ätherische Öle von der Pflanze) in die Nase, von dort über Riechzellen in den Riechkolben des Gehirns. Dort Weiterverarbeitung zu den Zentren "Gefühle" und "Verhaltensweisen". Die Bedeutung solcher Öle für die Pflanzen selbst ist umstritten. Es wird angenommen, dass die Öle beim Verdunsten die Wasserabgabe durch die Blätter verringern. Dies würde verständlich machen, dass Mittelmehrpflanzen in der Mittagshitze besonders stark duften. Die ätherischen Öle verhindern auch Insektenfraß, sie bilden einen Schutz gegen Weidetiere, zum Teil wirken sie auch antibakteriell. Für den Menschen spielt nur der Geruchseindruck eine Rolle. Viele pflanzliche Duftstoffe sind daher in Parfüms enthalten. Wegen der teuren Gewinnung sind die Preise für die Essenzen, die reinen ätherischen Öle, sehr unterschiedlich: z.B. kostet ein Kilo Rosenöl (Bulgarien) rund 4000 Euro, ein Kilo Orangenöl (aus Florida) nur rund 5 Euro. Im Versuch wird aus der Duftgeranie Geraniol durch Wasserdampfdestillation gewonnen und durch Riechen nachgewiesen. Technik: Von den rund 3000 bekannten Duftstoffen aus Pflanzen – meist aus Blüten - werden nur rund 150 Stoffe industriell genutzt. Die wichtigsten Duftstoffe sind sog. „ätherische Öle“, die besonders rasch schon bei Zimmertemperatur verdampfen und deswegen zu riechen sind. Andere Methoden der Duftstoffgewinnung sind: Mazeration: Einbringen von Pflanzenteilen in einen geschlossenen Raum mit tierischen, leicht zu verflüssigenden Fetten (wie Schweinefett). Die Duftstoffe diffundieren langsam in das Fett, aus dem sie leicht durch vorsichtiges Erwärmen wieder freigesetzt werden können. Enfleurage: Auf Glasplatten mit Hammelfett werden 5mal nacheinander frische Rosenblätter aufgebracht, bis das Fett mit den Duftstoffen gesättigt ist. Extraktion: Die Duftstoffe werden mit Petroläther ausgewaschen, der Petroläther verdampft und das ätherische Öl bleibt sehr rein übrig. Eine technische Weiterentwicklung stellt die Druckextraktion mit verflüssigtem Gas dar. Lit: Probst, W (1984): Parfüm aus Pflanzen IN: UB 90, 8, Jahrg; Müller, J. (1984): Das H&R Buch Parfüm, Glöss Verlag, Hamburg; Barille; E. und Ch. Laroze: Parfüm, Christian Verlag neuste Auflage https://de.wikipedia.org/wiki/Parf%C3%BCm | ||
Versuch 1
Demonstration von Ätherischen Ölen
Test: Man nimmt ein Stück einer Apfelsinenschale und drückt das Stück vor der brennenden Kerze aus:
Aufleuchten der Flamme und Hinwendung zur Schale zeigen das Verbrennen von ätherischen Ölen an.
Aufgabe: Verfolge den Weg der Duftstoffe in das Gehirn!


Versuch 2
Wo kommen die Duftstoffe her?
Wir entdecken besondere Organe in Blättern!
Was wird gebraucht:
Eine Duftgeranie (Fachgeschäft)
Rasierklingen
Mikroskop mit Objektträgern
und Deckgläschen
und Deckgläschen
Arbeitsgang zur Beobachtung der Duftdrüsen
Aufgabe: Fertige eine möglichst große Zeichnung des „Behälters“ der Duftstoffe an!

Arbeitsablauf:
1. Eine Seite der Rasierklinge wird mit Haftband beklebt, damit man sich nicht schneidet.2. Von der Blattunterseite macht man parallel zur Oberfläche an der Blattader einen möglichst dünnen Schnitt;3. Man überträgt das abgeschnittene Gewebestück in Wasser vorsichtig auf einen Objektträger;4. Vorsichtiges Auflegen eines Objektgläschens;5. Beobachtung im Mikroskop.

Versuch 3
Destillation des Duftstoffs
Was wird gebraucht?
1) Ein Topf mit einer Duftgeranie
2) Eine Destillationsanlage wie in der Abbildung gezeigt.


Wasserdampfdestillation von Duftstoffen
Man nimmt etwa 200g frische Blätter einer Duftgeranie. Der Kolben mit Wasser wird langsam erhitzt. Schon sehr rasch scheidet ich im eisgekühlten Auffangkolben auf einer Wasseroberfläche das Duftöl Geraniol ab.
Test: Geruchsprobe
Weitere geeignete Pflanzen oder Pflanzenteile sind:
Duftnelken aus dem Gewürzhandel, Salbeiblätter, Apfelsinenschalen
Zur Geschichte der Düfte - kurz gefasst
Duftstoffe Die Nutzung von Düften ist so alt wie die Menschheit. Duft ist der Inbegriff der Verfeinerung des Lebens. Noch bevor die Menschen anfingen, sich selbst, ihre Geräte und ihre Umgebung durch Bemalen zu schmücken, machten sie sich den Göttern angenehm – durch Duft. Zu Beginn nutzten sie einfach Blumen, die besonders gut duften, aber bald entdeckten sie, dass Harze und Balsame durch Erhitzen noch stärker riechen: Per fumum = „durch Rauch“, durch Rauchopfer suchte man sich der Gottheit zu vergewissern. Man opferte das Teuerste, das man hatte, erst noch Tiere, dann aber mehr und mehr Zubstaanzen, die bei Erhitzen besonders gut duften. Ein Relikt aus diesem kulturellen Zusammenhang ist die Nutzung von Weihrauch im katholischen Ritus. Der Mensch bemerkte gleichzeitig, wie wichtig Düfte für ihn selbst sind. Das Zubereiten und Konservieren von Duftstoffen sind seit dem 4 Jahrtausend vor Christus nachgewiesen. Durch die Römer kam die heutige Bezeichnung für die Kombination von Duftstoffen: „Per fumum“ wurde zu „Parfüm“. Im alten Rom war der Bedarf an Duftstoffen gewaltig, es wurde alles parfümiert, was nur irgend mit Duft zu versehen war: Badewasser, Haare, Haut, Kleidung, Bett, die Personen selbst,das beste Pferd, die Wände der Zelte… Es gab Parfüms gegen Mundgeruch, gegen Körperdüfte, gegen Gestank in der Wohnung. Diese Kultur des guten Geruchs geriet mit dem Niedergang Roms und mit dem Aufkommen des Christentums in Misskredit. Während die Bibel und der Koran Räucherwerk und Badegewohnheiten als Bestandteile des täglichen Lebens positiv beschreiben, wurden im Zeichen des christlichen Lebens Körper und Hygiene weniger geachtet und die Nutzung die teueren Duftstoffe als Zeichen der Eitelkeit verteufelt. Es blieb der Weihrauchduft, der den Kirchen vorbehalten war. In dieser Zeit war besonders in Arabien die Kunst des Parfümierens verbreitet. Erst um 1200 kam die Kunst des Parfüms durch die Kreuzritter nach Mitteleuropa. Venedig organisierte den Handel. Da die Araber schon die Destillation erfunden hatten, mussten nicht mehr die getrockneten Pflanzenteile importiert werden, sondern die Destillate, die Essenzen, wurden in kleinen Glasfläschchen eingeführt, zu horrenden Preisen, versteht sich. Daher rührte ein Teil des Reichtums von Venedig - neben dem Gewürzhandel. Seit dem 19 Jahrhundert entwickelte sich die Stadt Grasse im Departement Alpes-Maritimes zur Welthauptstadt der Essenzen mit mehreren großen Firmen. Hier wurden die Verfahren der Duftstoffgewinnung in großtechnischem Maßstab optimiert. Mit dem Aufkommen der synthetischen Duftstoffe wurde die deutsche Stadt Holzminden nach dem zweiten Weltkrieg Weltmarktführer (Firma: Haarmann&Reimer). Die synthetischen Duftstoffe lösen keine allergischen Reaktionen aus und die Auswahl der chemischen Synthesen ist nahezu grenzenlos. Zum Beispiel besteht das berühmte und teure Parfüm Chanel Nr5 - das erste Parfüm aus ausschließlich chemisch synthetisierten Substanzen - aus 80 verschiedenen Düften bei 85% Alkoholgehalt. Es wurde vom Parfümeur des russischen Zaren für die Modedesignerin Chanel entwickelt. Heute hat jeder Modedesigner ein eigenes Parfüm und verdient oft mehr am Parfüm als an den Kleidern. Dazu wird fast jedes Produkt mit einem eigenen Duft versehen, bevor es in den Handel kommt. Denn: was nicht riecht, wird nicht gekauft. Und was schlecht riecht, schon gar nicht. Arbeitsplatz eines Parfümeurs  In der Parfümindustrie gibt es einen besonderen Beruf: Personen, die besonders gut riechen können, heißen: „Die Nasen“. Sie sind besonders geeignet, aus den verschiedensten Düften, den sogenannten Essenzen, immer wieder neue Parfüms zu erfinden. Literatur: Süßkind, P: (neueste Auflage), Das Parfüm, Diogenes Verlag; Jellinek, J. St. (2000): Parfüm, der Traum im Flakon, GoldmannVerlag; http://www.myparfuem.com/Wissen/3/201/Parfuemgeschichte/Damals-Und-Heute.html Schöner, H. (1983): Parfüm im Wandel der Zeiten, Hans-Schöner-Verlag; Müller, J. (1984): Das H&RBuch Parfüm, GlössVerlag, Hamburg ; | ||
Versuch 4
Wir stellen ein Parfüm her!
Ausgangsstoffe:
Besorge aus der Apotheke oder aus einer Drogerie verschiedene Duftstoffe. Achte darauf, dass es reine Düfte sind und keine Mischungen!
Versuch 1: Erkennen von Düften:


Versuch a: Mische ein Parfüm aus den gekauften Essenzen, das Dir gefällt.
1. Fülle 2ml absoluten Alkohol in ein 10ml Deckelglas2. Entnehme mit einem Glasstab einige Tropfen aus einem Glas mit den Essenzen!3. Rühre im Deckelglas mit dem Glasstab gut um.4. Rieche und prüfe sorgfältig5. Entscheide Dich für die nächste Essenz (mit sauberem Glasstab natürlich!!)6. Rühre gut um, rieche und Beurteile erneut;7. Führe die Komposition solange fort, bis das „Superparfüm“ fertig ist.
Erfinde einen Namen: ________________________________________
Lass andere dein Parfüm bewerten!!!
Bewertungsbogen:

Du hast 10 Punkte zu vergeben, gib dem getesteten Parfüm eine Anzahl von Punkten! Teste wenigstens 4 andere Parfüms! - Das Parfüm mit den meisten Punkten hat wahrscheinlich den höchsten Verkaufserfolg!
Antibiotika aus Pflanzenblättern
Schätzle, Cl., V. Uhl u. V. Schneider
Nutzung von Stoffen aus Pflanze Das Prinzip der Trennung organischer Substanzen aus Pflanzenmaterial kann mit diesem Versuch erprobt werden. Gleichzeitig wird Detektivarbeit verlangt und ermöglicht. Dies dürfte zur Motivation beitragen. Die Gegenwartsbedeutung des Verfahrens erscheint recht hoch: In der Forschung werden zunehmend Inhaltsstoffe aus Pflanzen für die medizinische Forschung interessant. Zurzeit werden etwa 20000 Pflanzen für die Herstellung von (illegalen) Drogen, Arzneimittel, oder für Parfüme und Salben genutzt. Man sucht besonders bei tropischen Pflanzen nach bisher unbekannten Inhaltsstoffen.  Kapuzinerkresse KapuzinerkresseDieses Experiment mit Kapuzienerkresse eignet sich für den anspruchsvollen Biologie- oder Chemie- Unterricht.. Es verlangt sehr sorgsames und überlegtes Arbeiten über einige Zeit hinweg. Die verwendete Pflanze ist die Kapuzinerkresse, die sich leicht in einem Pflanzkübel über 8 Wochen heranziehen lässt. Ein Versuchsergebnis: Petrischale mit Normalgar in Aufsicht Vgl: Schätzle, C. V.Uhl u V. Schneider: Ein Antibiotikum aus der Kapuzierkresse PiN-Biol. 3/48 Jahrg 1999; http://naturmedizin-alternativmedizin.suite101.de/article.cfm/meerrettich_und_kapuzinerkresse Pharmaforschung: www.vfa-bio.de 2010-05-01; weitere Informationen im Internet Pharmaforschung: www.vfa-bio.de | ||
Versuch 5
Anreichern und Nachweis eines Antibiotikums (Senföl?)
Geräte:
Eine Apparatur für Wasserdampfdestillation nach Abbildung, Schütteltrichter
Material:
300g Blätter von Kapuzinerkresse, Wasser, Ether
Durchführung:
1) Zusammenbau der Apparatur2) Erhitzung von etwa 60ml Wasser in Kolben 1. Wasser muss nach und nach zugegeben werden.2) In einem zweiten großen Rundkolben werden die frischen Blätter mit Wasserdampf durchsetzt. Ein Vertrocknen der Blätter ist unbedingt zu vermeiden. Man erhitzt solange, bis Wasserdampf sich im Liebigkühler niederschlägt.3) Im Eisbad wird möglichst viel Extrakt aufgefangen.4) Der Extrakt wird in einen Schütteltrichter überführt und möglichst wenig Ether zugegeben, bis eine sehr dünne Etherschicht entsteht.Wegen des Ethers unbedingt unter dem Abzug arbeiten!!

5) Man stanzt mit einem Locher runde Stücke aus gutem saugfähigem Papier aus, steriliesiert sie unter einer Höhensonne 20 min lang und bewahrt sie in einem sterilen Behälter auf. (Glasgläschen mit Deckel, das man zuvor im Ofen 2o min bei 120 Grad erhitzt und trocken abgekühlt hat. Die Deckel lassen sich in kochendem Wasser in 20 min ebenfalls sterilisieren.)
6) Man nimmt möglichst viel Etherschicht mit den Papierstücken auf, lässt den Ether verdunsten und verwendet die Papierstanzen für den Versuch.
Versuch 6
Nachweis und Auswertung:
Material: Sterile Petrischalen aus Plastik oder Glaspetrischalen, die man zuvor bei 120 Grad Celsius 20 min lang im Ofen sterilisiert hat, Test-Bakterien (Bakterien (Bacillus subtilis, Merk, Darmstadt) Käufliche Salbe oder Lösung mit einem Antibiotikum als Kontrolle.
Vorbereitung:
1) man lässt die Petrischalen auf etwa 40 Grad erkalten2) Normal Agar-Agar- Lösung wird nach Vorschrift angesetzt, im Dampfkochtopf bei 120 Grad 30 min lang sterilisiert. Man lässt abkühlen und rührt bei etwa 40 Grad Celsius 0,1 ml Sporensuspension von gentechnisch veränderten Bakterien (Bacillus subtilis, Merk, Darmstadt) ein. Diese sind für den Menschen ungefährlich. Dann füllt man je 15 ml in zuvor im Backofen bei 120 Grad Celsius 30 min lang sterilisierte Petrischalen ein und lässt erkalten. Die Platten halten sich einige Tage im Eisschrank.
Die Papierstücke stanzt man mit einem Locher aus Fließpapier, die man anschließend unter der Höhensonne etwa 1 Stunde sterilisieren lässt.
Test auf Antibiotika-Wirkung
Auf eine fertige Agarplatte gibt man
a) eine sterile Stück Fließpapier (Locher) mit Wasser getränktb) eine steriles Stück Fließpapier mit Ether getränkt und getrocknet.c) ein steriles Stück Fließpapier mit dem Kresse-Extrakt getränkt.d) ein steriles Stück Fließpapier mit einem Test-Antibiotikum getränkt.

Auswertung: Nach zwei bis drei Tagen bei Zimmertemperatur entwickelt sich ein „Bakterienrasen“, der der Platte ein trübes Aussehen verleiht.
Dort, wo keine Bakterien wachsen (Hofbildung) muss eine wachstumshemmende Substanz aus den Filterplättchen in den Agar diffundiert sein. Bei Wasser und Ether dürfte sich kein Hof bilden.
Erytromecin ist ein Antibiotikum (Apotheke), hier zu Testzwecken in minimaler Dosis genutzt.
Informiere dich aus dem Internet über andere Wirkstoffe aus Pflanzen und Algen und deren Bedeutung in Medizin und Kosmetik!
Biotechnik 4: Substanzen zum Färben
Schneider, G.
Farbstoffe Substanzen, die Licht absorbieren können und das Licht in einer anderen Wellenlänge wieder abgeben, erscheinen dem menschlichen Auge als „farbig". So wird vom Chlorophyll der Pflanzen die Blau- und Rotlichtanteile des eingestrahlten Weißlichtes absorbiert, die restlichen Wellenlängen werden wieder abgestrahlt: Blätter erscheinen daher „Grün". Farbigkeit hat die Menschen immer fasziniert. Sie bemalen ihr Gesicht mit Farbstoffen bis heute, die ältesten bildlichen Darstellungen sind mit Mineralfarben und Asche verstärkt. Z.B.: Färbemöglichkeiten mit Kastanienblättern  Färbmöglichkeiten Mit der Fähigkeit Stoffe weben zu können, gab es Bemühungen, Garne oder die fertigen Stoffe zu färben. Bis zur Erfindung der synthetischen Farbstoffe seit 1858 benutzte man Inhaltsstoffe aus Pflanzen und Tieren zur Färbung von Textilien. Das war technisch aufwändig und die Rohstoffe aus Pflanzen und Tieren (wie Schnecken), waren begrenzt. Farbige Textilien konnten sich daher nur wenige Reiche leisten. Der Aufschwung der Chemischen Industrie begann mit der Erfindung synthetischer Farben, die auf Geweben haften bleiben. Purpur- die Farbe der Könige: Der Purpur ist ein Beispiel für die Kostbarkeit gefärbter Textilien im Altertum. Man gewann ihn in einem langwierigen Verfahren aus den schleimigen Absonderungen bestimmter Meeresschnecken (z. B. Murex brandis) und konnte damit leuchtende, haltbare Rottöne erzeugen. 8000 Schnecken mussten ihr Leben für 1g Farbstoff lassen. 1kg bester Purpurwolle kostete nach heutigem Wert etwa 4000€. Meterhohe Ablagerungen von Schneckengehäusen vor der Küste Libanons zeugen noch immer von der hier im Altertum blühenden „Purpur-Industrie". Als sich das frühe Christentum gegen den verbreiteten Kleiderluxus wandte, ging die Nachfrage immer weiter zurück. Preiswertere rote Farbstoffe aus Kermesläusen und aus den Wurzeln der Krapppflanze lösten im frühen Mittelalter den Purpur ab. Damit verbunden waren neue Entwicklungen in den Färbetechniken und die Entstehung neuer Färbezentren in Mitteleuropa (zum Beispiel die Weltfirma IG Farben). Färben: Färben heißt die möglichst dauerhafte Übertragung eines Farbstoffs auf eine Unterlage, hier eine textile Faser. Man unterscheidet: tierische Fasern wie Wolle und Seide, pflanzliche Fasern wie Baumwolle und Leinen und Kunststoffe. Wegen der unterschiedlichen chemischen Struktur benötigt jede Fasergruppe auch spezielle Farbstoffe und besondere Färbemethoden. Die hier vorgeschlagenen Methoden sind nur eine kleine schulgerechte Auswahl, die ohne Giftstoffe auskommt. Farbqualität: Im Prinzip leistet keine Färbung alle Kriterien zu 100%. In der Forschung kommt es heute darauf an, die Echtheitskriterien bei Farbstoffen zu optimieren. LIT: Schneider ,G(1979): Färben mit Naturfarben, Ravensburg; Schneider, G. (1986): Färben mit Naturfarben früher und heute, IN: Textilarbeit und Unterricht Verlag Burgbücherei Schneider; Schweppe; H: (1993): Handbuch der Naturfarbstoffe Ecomed; Wikipedia – Indigo (2010): http://de.wikipedia.org/wiki/Indigo 2010-07-26;CH. Bautsch (2001): Blaufärben mit Indigo IN: http://www.bautschweb.de/chemie/blaumach.htm 2010-07-26; | ||
Versuch 7
Farbstoffe aus Flechten als Färbemittel für Wolle
Benötigt werden: Wollwaschmittel, Wolle, 6 Liter Topf, vorbereitete Färbflotte
Erster Schritt: Waschen des Färbeguts (Wolle)
Richtiges Waschen der Wolle: Die Fasern nicht gegenseitig vernetzen sondern eher
die Fasern parallel ziehen.
die Fasern parallel ziehen.
Zweiter Schritt: Farbstoffe aus dem Isländisch Moos herauslösen.
Was wird benötigt?
Ca 300g getrocknete Flechten („isländisch Moos“ in Apotheken)
Eine Waage, einen 6 Liter Topf, ein Mulltuch oder eine Windel, Wasser
Was ist zu tun?
Für die Flotte (= Färblösung) braucht man 300g getrocknetes Isländisch Moos (Flechten) oder 500g frisches Material.
Einweichzeit Flechten 6 Stunden, Kochzeit: 2 Stunden


1. Herstellung des
Flechtenextraktes ("Flotte")
2 Färben der Wolle
mit Flechtenextrakt
Versuch 8
Färben mit Farbstoff aus Birkenblättern
Was wird benötigt?
200 Gramm Getrocknete Birkenblätter (als Tee in Apotheken) oder 400 g frische Blätter, eine Waage, einen 6 Liter Topf, Mulltuch oder Windel, Wasser
Was ist zu tun?


1. Extraktion aus Birkenblättern
(Herstellung der Flotte)
2. Färben der Wolle
Versuch 9
Färbungen haftbar machen: Beizen mit Alaun
Unter Beizen versteht man die Anlagerung von Salzen, die eine haftende Verbindung zwischen Wollfaser und Farbstoff herstellen.
Benötigt werden:
15g Alaun (KaAl (SO4)2 x12 H2O) für 100g Färbegut (Wollgarn oder Rohwolle),
400g frische Kastanienblätter,
Wollwaschmittel, Wolle, 6 Liter Topf, Waage, Bechergläser
Erster Schritt: Waschen des Färbeguts (Wolle)
Richtig Waschen:
Die Fasern nicht gegenseitig vernetzen, sondern beim Waschen die Fasern parallel
auseinander ziehen.

Zweiter Schritt: Herstellung der Beizlösung
Das Beizen mit Metallsalzen verbessert die Verbindung zwischen Farbstoff und Faser. Hier eine unbedenkliche Beize: Alaun (Natrium-Aluminium-Sulfat).
Die anderen Beizen sind giftig. Die gebeizte Wolle muss getrocknet werden.
Dritter Schritt: Herstellung einer Flotte mit den gewählten Blattmaterial
Das Blattmaterial kann man freu wählen. Ein Vergleich zwischen üblicher Färbung und Beizenfärbung bietet sich an.
Vierter Schritt: Beizfärbung der Wolle
Benötigt werden: 100g getrocknete oder 300g frische Kastanienblätter, Mulltuch oder Windel, Wasser, 100g gebeizte Wolle, Färbflotte Waschlauge mit Vollwaschmittel. Die nun gefärbte Wolle muss an der Luft getrocknet werden, damit sie nicht verfilzt.



Beizen von Wolle
mit Alaun
Herstellung einer Flotte
aus Blattmaterial
Beizenfärbung
mit einer Flotte
Versuch 10
Qualität der Färbung
Die gefärbte Wolle, das gefärbte Tuch kann noch so schön sein, wichtig sind auch die Gebrauchseigenschaften. Man verlangt von einer gebrauchsstabilen Färbung von Kleidungsstücken oder Garnen die folgenden Eigenschaften:
1) Ungiftigkeit Ungiftigkeit wird nicht immer eingehalten. Öfter entstehen Allergien. Mit schulischen Mitteln sind Gifte nur sehr schwer nachzuweisen.
2) Lichtechtheit
Das Sonnenlicht sollte die Farbe nicht ausbleichen.
Das Problem ist: das eingestrahlte Sonnenlicht, vor allem die UV-Anteile sind sehr energiereich. Gefärbte Substanzen erwärmen sich daher stärker als eine weiße Fläche.
(Test: Man, lässt Sonnenlicht auf eine weiße und eine schwarze Fläche scheinen und misst nach 5min die Temperatur an den Oberflächen.)
Ein erster Test erlaubt eine Abschätzung: Man bereitet sich einige weiße Kartons
mit der zu testenden Faser wie abgebildet und deckt einen Teil mit schwarzem Karton ab. Nach 6 Wochen Sonnenlicht zeigen sich Unterschiede
Eine 100%ige Lichtechtheit ist unmöglich. Man hat sich auf 4 Stufen der
Lichtechtheit geeinigt.
Stufe 4 (höchste Stufe): “indantren”
Die Proben d e f sind nicht aussreichend lichtecht!


3) Reibechtheit
Ein anderes Problem ist die Reibechtheit. Durch Reiben auf einer weißen Unterlage kann man leicht die Haftung des Farbstoffs auf der Textilfaser überprüfen. Es ergeben sich erhebliche Unterschiede, auch bei gekauften Textilien.
Probe b ist nicht reibecht.
4) Waschechtheit
Man, verlangt natürlich eine möglichst lange Haftung der Farbe auch nach Einwirkung von Schweiß und nach häufigem Waschen. Die Waschechtheit kann man ebenfalls leicht überprüfen, indem man wie vorgeschrieben wäscht und die Farbe einer frischen Waschlauge mit einer gebrauchten Lauge vergleicht.
Aufgaben: Prüfe verschiedene Kleidungsstücke, Stoffe und die selbstgefärbten Woll-, Seiden- und Baumwoll- Fäden im Hinblick auf diese Kriterien!
Färben mit Indigo
G. u. V. Schneider
Indigo Info: Der Farbstoff aus Pflanzen spielte und spielt bis heute eine große wirtschaftliche und wissenschaftliche Rolle. Die Möglichkeit, Indigo chemisch herzustellen, war ein wesentlicher Startpunkt für die chemische Industrie in Deutschland. Die Erfindung ließ den Handel mit Indigo aus Indien verkümmern. Noch heute ist die Bedeutung in der Namengebung: IG Farben zu erkennen. Die heute billig käufliche Indigosubstanz muss zunächst reduziert werden, damit sie sich in Wasser gelb-grünlich löst. Dies wurde im Mittelalter durch Erhitzen und Zugabe von Urin bewerkstelligt. Wegen des Gestankes mussten die Gerber außerhalb der Stadtmauern tätig sein. Bis heute gibt es die Färbergassen in vielen Städten. Aus der Wirtschaftsgeschichte: Blaufärben mit Indigo Schneider, V. Isatis tinktoria war lange Zeit in Mitteleuropa die Pflanze, mit der man Stoffe blau färben konnte. Sie war bis ins späte Mittelalter der wichtigste Lieferant des blauen Farbstoffs. So schön der Farbe auch war, die Herstellung war weniger angenehm:  Waid die Kulturpflanze für das Blaufärben im Mittelalter (aus Ciba Rundschau Basel 1936 / 37 und Ploss: Ein Buch von alten Farben Der Chemiker R. Reiking hat das Rezept aus dem Papyrus Holmiensis (3tes Jahrhundert nach Christus) bearbeitet: „Schneide den Waid ab und sammle ihn im Schatten in Körbe. Dann zerkleinere das Kraut und lass es den ganzen Tag stehen. Am folgenden Tag durchlüfte es und geh darin herum, damit es durch die Bewegung der Füße aufgeworfen wird und gleichmäßig trocknet. Dann sammle es zur Aufbewahrung in Körbe. Fülle etwa 25 kg des trockenen Materials in einen Kübel, der in der Sonne steht, von mindestens 600Liter Inhalt und schichte es gleichmäßig auf. Dann gieße so viel Harn darauf, bis die Flüssigkeit übersteht, und lass die Masse in der Sonne warm werden. Am andern Tag schließe sie dadurch auf, dass du in der Sonne darin herumtrittst, bis sie gleichmäßig durchgezogen ist. Das muss 9 Tage lang geschehen." Die hierbei entstehenden heftigen Gerüche waren einer der Gründe für das geringe Ansehen, das die Färber zu fast allen Zeiten genossen. Und weiter heißt es:
 Indigopflanze IndigopflanzeHalbindustrielle Herstellen von Indigo auf den Antillen  Beim Färben muss der Indigo in der Küpe wieder in die lösliche Form gebracht werden, um auf die Faser aufziehen zu können. Die Verfahren dazu sind immer wieder verbessert worden und reichen bis zur modernen Hydrosulfitküpe (vgl. Indigo-Färbung). Die Waidbauern Europas merkten sehr bald den Druck der Konkurrenz, und durch manche Verbote des Indigos versuchte man den Waidanbau zu retten. Große Wirkung scheinen die Verbote nicht gehabt zu haben. So klagt der Chemiker J. Becher aus Speyer 1682: „... so gehen unsere Manefakturen auch mehr hinter sich als vor sich, sie geben nur das Geld an die Holländer vor und lassen hingegen den WaydBau in Thüringen zu Grunde gehen." Auch spätere Versuche unter Napoleon I., den Waidanbau wieder zu beleben, führten zu keinem Erfolg: Der Indigo blieb Sieger. Als die absolutistischen Staaten im 17. Jahrhundert immer mehr Geld für ihre Staatskasse brauchten, unterstützten sie die Entstehung größerer, rationell arbeitender Betriebe. Berühmt wurde Colbert, der zur Zeit Ludwigs XIV. die französische Wirtschaft unter dem Gesichtspunkt höchsten Gewinnes und Steueraufkommens neu organisierte. Die Entwicklung zur industriellen Produktion wurde aber nicht nur durch wirtschaftliche Anstrengungen in Gang gesetzt, wichtiger wurde die Weiterentwicklung der Chemie von der Alchemie zur naturwissenschaftlichen Disziplin. Wesentlich daran beteiligt war Justus von Liebig, der als genialer Chemiker und Erfinder an der Universität Gießen wirkte. Dieser vielseitige Forscher erzielte seine größten Erfolge mit der Entdeckung der künstlichen Düngung. Um auf dem Laufenden zu bleiben, verteilte er an seine Schüler Arbeitsaufträge aus allen Gebieten der Chemie. Als Liebig von einem ehemaligen Studenten ein Stück Steinkohlenteer bekam, beauftragte er seinen 23jährigen Assistenten A. W. Hoffmann mit der Untersuchung. Hoffmann fand einen farblosen Bestandteil, den vor ihm schon Runge entdeckt hatte. Er konnte nachweisen, dass die von Fritsche aus dem Indigo gewonnene Substanz Anilin (nach dem portugiesischen Namen des Indigos „anil") mit der von ihm aus dem Steinkohlenteer isolierten identisch war. Das war die Geburtsstunde der IG Farben AG Diese Firma wurde weltweit führend und brachte Deutschland einen ungeheuren wirtschaftlichen Aufschwung. | ||
Versuch 11
Färben mit Indigo
Was wird benötigt?
1. etwa 50g Wolle als Garn oder als Rohwolle2. Topf für das Reinigen der Wolle,3. Waschmittel4. Glas Gefäß für Stammküpe5. Topf für Färbeküpe (3 Liter)6. Indigo- Farbstoff (Chemiekalienhandlung handlung oder Livos: versand@livos.de)7. Netzmittel (Pril)8. Reduktionsmittel (Natriumdithionit)9. Natriumkarbonat10. 25%ige Essigsäure (Essigessenz)
Was ist zu tun?
1 Reinigung der Wolle: bei 700 mit Feinwaschmittel waschen, gut auswaschen und feucht halten;
2 Herstellung der Stammküpe:
Vorsicht: Schutzbrille, Schürze und Gummihandschuhe tragen!
- 1,5g Indigopulver werden mit 7 ml Wasser und etwas Pril zu einer Paste verrührt;
- In einem zweiten Gefäß werden 3gr Natriumcarbonat in 12ml warmem Wasser aufgelöst,
- . 6 bis 7 ml dieser Lösung werden mit der Indigopaste verrührt,
- Zugabe von 3g Natriumdithionit, umrühren;
- Zugabe von 100ml warmem Wasser, gut vermischen;
- Diese Mischung auf 550 erwärmen und 20 min auf dieser Temperatur halten (auf keinen Fall über 600 !!);
- Die Flüssigkeit sollte nun eine gelbgrüne Farbe aufweisen.
- Wenn nicht, noch weiter Natriumdithionit zugeben.
- Zugabe von 3g Natriumdithionit auf die Oberfläche um die Rückoxidation durch Luftsauerstoff zu verlangsamen.
Die Stammküpe muss eine grün-gelbe Färbung annehmen.
3 Herstellung des Färbbades:
- 2 L Wasser auf 50o erwärmen;
- 1,5 ml 25%ige Ammoniaklösung und 1g Natriumdithionit zugeben;
- Von der Stammküpe 50ml vorsichtig zugeben, wenn möglich mit Pipette an den Grund des Gefäßes;
- Das Färbbad muss grün-gelbliche Färbung annehmen, etwa 20 min warten, andernfalls noch etwas Natriumdithionit zugeben.
- Den pH- Wert 8 mit pH-Papier auf 8 überprüfen, andernfalls mit etwas Essigsäure oder Ammoniaklösung einstellen.
4 Färbung der Wolle:
- Die feuchte Wolle einlegen und vorsichtig unter die Oberfläche der Färbe Küpe drücken.
- Nach ca. 4min in der Küpe mit Gummihandschuhen oder einem Löffel oder Draht herausnehmen.
- Die Verfärbung nach Blau findet an Luft statt.
- Auswaschen in warmen Wässern
5 Absäuern:
Zwei Liter Wasser mit 2 ml 25%iger Essigsäure auf 400 erwärmen, die gefärbte Wolle einlegen, weiter bis auf 800 erwärmen und 10 min auf 800 halten.
Abkühlen und ausspülen

Entstehung des Indigo-Blau
an der Luft
Abnahme der Farbintensität
nach aufeinander folgenden
Tauchgängen in
derselben Küpe

Reaktionen

1) Reduktion des unlöslichen Indigos:
1a) Oxidation des Natriumdithionits: Dithionit + 4OH- ==> 2 Sulfit + 2e- + 2H2O1b) Reduktion des Indigo: Indigo + 2 e- ==> Leucoindigo2-
2) Rückoxidation des Leuco-Indigos an Luft:
Leuko-Indigo2-- + O2 + 2 H2O ==> 2 Indigo + 4 OH -


Dithionit
Sulfit
Aufgaben:
Stelle die genaue Reaktionsgleichung auf!
Teste auf Reibechtheit, Test auf Farbechtheit, Test auf Waschechtheit

